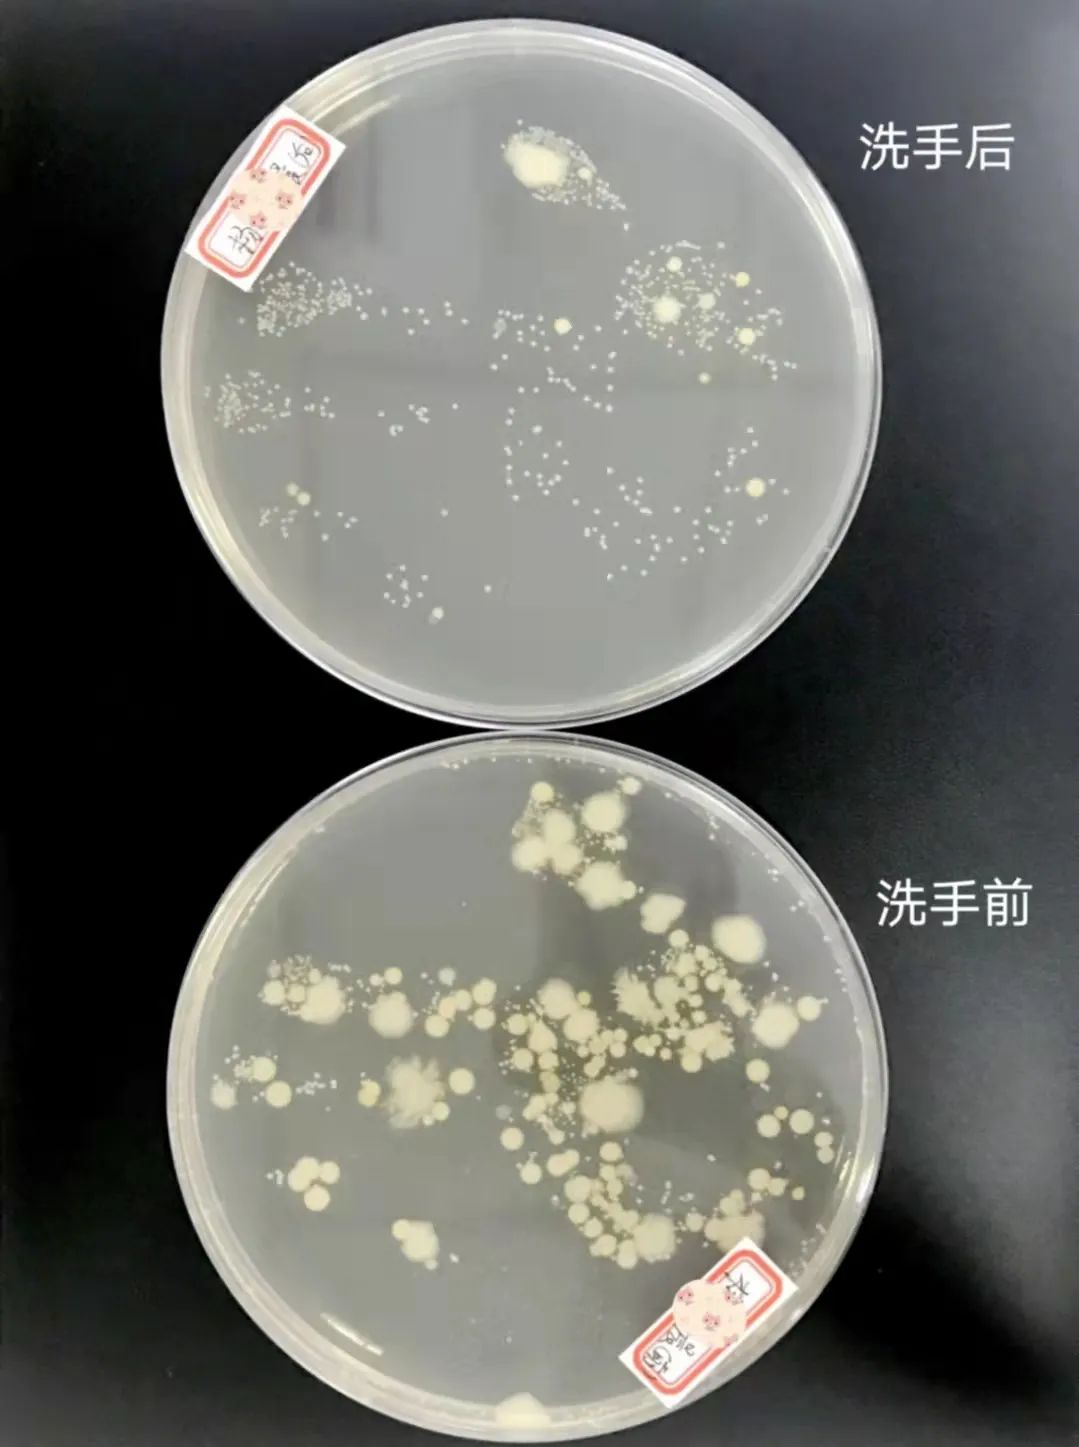
小小习惯大健康,科学洗手伴成长
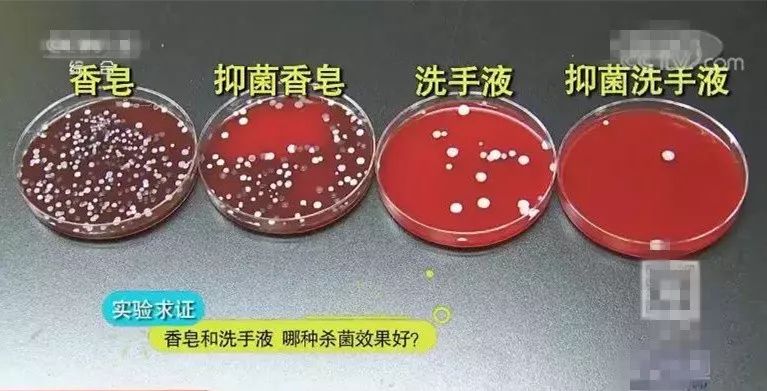
香皂,洗手液到底该选哪个好?你绝对想不到,最佳选择是._细菌

洗手前后的细菌图片

但还是有很多;用香皂认真洗手并擦干后,肉眼看不到细菌生长!
图片尺寸609x278
"手"护健康,从正确洗手做起_双手_进行_细菌
图片尺寸824x803
小小习惯大健康,科学洗手伴成长
图片尺寸1079x1423
(经过24小时的恒温)学生做洗手前后接种细菌和真菌的对照实验现象
图片尺寸1440x1080
小小习惯大健康,科学洗手伴成长
图片尺寸1079x1447
科普知识——正确洗手,"手"卫健康|细菌|毛巾|肥皂|消毒剂|洗手液
图片尺寸660x882
型疾病是通过手传播的;院内感染30%~80%是由手上的细菌经接触传播引
图片尺寸588x531
部卫生区别下面是小组成员的手部细菌培养皿,事实证明洗手的作用很大
图片尺寸750x1000
图为洗手前后手部细菌培养对比检验科主要针对患者体液标本进行婚验
图片尺寸3739x2804
你的小手洗干净了吗?"世界洗手日"前夕,一起来学正确洗手
图片尺寸1440x1080
灞桥区江尹幼儿园开展"七步洗手法"预防春季传染病健康教育|细菌|预防
图片尺寸640x777
洗手能洗掉多少细菌?一个实验告诉你!
图片尺寸1000x750
洗手前用五个手指尖儿点的五个小点儿,一天过后就发现有细菌在逐渐
图片尺寸4032x3024
洗手真的能除去细菌吗把这5片面包给孩子看从此天天主动洗手拦都拦不
图片尺寸592x353
香皂,洗手液到底该选哪个好?你绝对想不到,最佳选择是._细菌
图片尺寸767x391
好宝宝,勤洗手,健康和你做朋友
图片尺寸2000x2000![亲自验证幼儿园老师教会的道理[可r]比较洗手前后细菌真菌的数量](https://imgs.wantubizhi.com/img/ADDA3C5D760C6828B77B505A29D43E83D92EC0A5361279AABF7730344E360653E3C9048D21AEBCC646CC16F470B2071655CFD2E4D1D2F32BF70C99761E4EC8093C59D9806BB23E4415ED341CD085353EA6B421EBFF68709FA451AC863973250D)
亲自验证幼儿园老师教会的道理[可r]比较洗手前后细菌真菌的数量
图片尺寸1080x1439
宝宝不爱洗手一招教你搞定他她附各品牌洗手液抗菌能力大比拼
图片尺寸1280x960
神奇小实验 洗手教育课,洗完手后看看手指上还有多少细菌. - 抖音
图片尺寸1280x1707
公民防疫基本行为准则①之勤洗手_细菌_双手_进行了调整
图片尺寸1024x914

![亲自验证幼儿园老师教会的道理[可r]比较洗手前后细菌真菌的数量](https://imgs.wantubizhi.com/img/ADDA3C5D760C6828B77B505A29D43E83D92EC0A5361279AABF7730344E360653E3C9048D21AEBCC646CC16F470B2071655CFD2E4D1D2F32BF70C99761E4EC8093C59D9806BB23E4415ED341CD085353EA6B421EBFF68709FA451AC863973250D)


